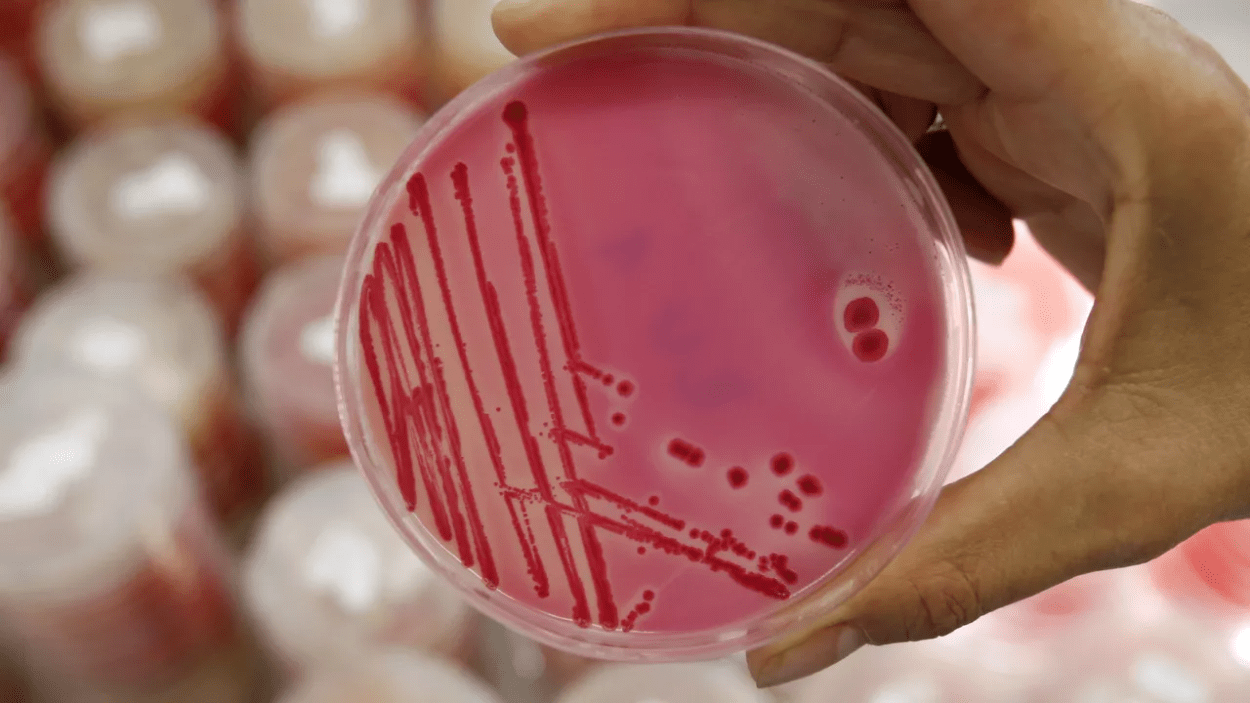

from thefreeonline on May 13, 2023 by Jonas E. Alexis at Investigative Committee | VT
“The United States aims to develop a universal genetically engineered biological weapon … Its use involves inflicting large-scale and irreparable economic damage on the enemy,”

By Jonas E. Alexis, Senior Editor
In February 2022, the Russian Defense Ministry discovered the existence of 30 US-funded military biological laboratories in Ukraine.
The Reports never say this but the ‘holy grail’ of Gain of Function Research is to develop genocidal viruses that only murder your enemy. This is one main reason for situating the Labs on the Russian borders, where fresh ethnic Russian DNA is available. A similar pattern can be surmised from the placing of the US genocide labs in Georgia, Uzbekistan and in Kazakhstan near Almaty as close a possible to China.
The work of Western biolaboratories in Ukraine may have been necessary to conceal the development of biological weapons, the head of the Russian Investigative Committee, Alexander Bastrykin, told Sputnik.

Alexander Bastrykin explained that the Convention on the Prohibition of the Development, Production and Stockpiling of Bacteriological (Biological) and Toxin Weapons stipulates that states parties undertake to take measures to prohibit such weapons within their territory.

However, according to Bastrykin, work in the field of microbiology using bacteria and viruses may have a dual purpose – both the development of medicines and the use of dangerous infections to create components of biological weapons.

U.S. Army’s main bioweapons research facility. Ft. Detrick, Md. from which researchers suspect the Covid-19 virus escaped [Source: goodmorningamerica.com]
The research that takes place in high containment labs is not only for disease prevention. CAM’s esposé of the CIA attack on Cuba with the African Swine Fever virus is a case in point… The dire implications of such research—which may also leak from labs—is magnified by the fact that this research can entail germ enhancement in the same way as “gain-of-function” health research… Most notably, the infamous Ames anthrax strain used in the “anthrax attacks” in 2001 derived from research to generate a highly virulent strain that would challenge vaccines; this research was conducted at Fort Detrick, Maryland
With world powers now in an unregulated Biowarfare Arms Race a disaster is more than likely. Indeed the panic over-reaction of China to the Covid-19 outbreak, and their massive lockdown (which was copied world wide) was certainly influenced by fear that the virus was designed to be lethal to the ethnic Chinese genome
For monitoring purposes, parties to the convention have to regularly provide information, such as what laboratories are operating on their territories and what facilities are involved in the research.

“But if one country uses the territories of other states to conduct research, such behavior could be seen as a desire to circumvent existing monitoring procedures and conceal the real aims and results of its activities.
As part of the criminal case, the Investigative Committee continues to analyze the available information related to the issue,” Bastrykin said when asked about the possibility of Western countries developing bioweapons in laboratories in Ukraine.
US Working on ‘Universal’ Genetically Engineered Bioweapon: Russian Parliamentary Investigation..
“The United States aims to develop a universal genetically engineered biological weapon capable of infecting not only people, but animals as well as agricultural crops. Its use involves, among other things, the goal of inflicting large-scale and irreparable economic damage on the enemy,” the commission wrote in its final report.
The Russian Security Council on April 12 unanimously approved the report of a parliamentary commission investigating the activities of US biolaboratories in Ukraine, and the document has already been supported by the State Duma.
In February 2022, the Russian Defense Ministry discovered the existence of 30 US-funded military biological laboratories in Ukraine. According to Moscow, Washington has spent over $200 million to develop biological weapons at the facilities.
Russia also said that the labs uncovered in Ukraine constituted only a small part of a global network of over 300 similar facilities. The Unites States denies the Russian accusations.
SOURCE The Intel Drop
Jonas E. Alexis, Senior Editor

This is Madness! ‘200 Bioweapons Labs in US’.. Must Be Shut Down and Scientists Prosecutedhttps://thefreeonline.com/2020/…
Related
- US Cover-Up of Pentagon’s Secretive Bioweapons Labs Poses Global Threat
- Kiev Conducted Experiments ‘With Extremely Dangerous Diseases’
- Russian Defense Ministry Probes 240 Dangerous Diseases Pathogens Found in 4 Ukrainian Labs
- US Bioweapons Labs Worldwide are a DANGER to HUMANITY …
- Synthetic COVID & Chimeric Strains: Why US Should Open All of Its Biolabs for Inspection
- Who Are the Americans Coordinating Bioweapons Research in Ukraine Labs?
- Bioweapon Labs Must Be Shut Down and Scientists Prosecuted By Joseph Mercola
US Working on ‘Universal’ Genetically Engineered Bioweapon: Russian Parliamentary Investigation
- US in Georgia creates bioweapon under the pretext of fighting viruses
- How Washington Fails to Sweep Ukraine’s Biowar lab Revelation Under Rug
- The deadly business of the Biden family
- US Cover-Up of Pentagon’s Secretive Bioweapons Labs Poses Global Threat